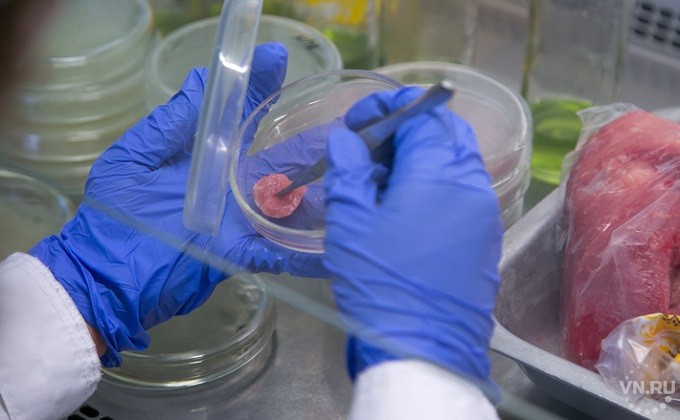

Лаборатория в новосибирске коронавирус
Всё про анализы на коронавирус: где сдать, сколько ждать результатов и можно ли скрыть диагноз
- 1. Какие тест-системы существуют?
- 2. Какие лаборатории делают тесты на коронавирус и сколько исследований сделано?
- 3. Можно ли утаить диагноз при платном тесте?
- 4. Как подготовиться к сдаче анализа? Можно ли пить, есть?
- 5. Через сколько будет готов результат?
Всё про анализы на коронавирус: где сдать, сколько ждать результатов и можно ли скрыть диагноз
Объясняем в 5 простых карточках
Лаборатория на базе Федерального исследовательского центра Фундаментальной и трансляционной медицины (ФИЦ ФТМ СО РАН)
Фото: Александр Ощепков
В Новосибирской области становится всё больше больных коронавирусом. Темпы прироста увеличиваются с каждым днем: в субботу выявили 10 больных, в воскресенье уже 22, в понедельник — 24. Сегодня, в среду, уже 16. Всего новым вирусом заболел 151 новосибирец, многие заразились в городе — они никуда не выезжали. У некоторых и вовсе не было симптомов.
Как провериться на коронавирус, если вас ничего не беспокоит и поводов для обращения к врачам нет? Можно ли сдать анализ без направления? Какие тесты делают в нашем регионе? Где и за сколько? Через сколько сообщают результат? И можно ли, сделав анализ в частной лаборатории, скрыть диагноз от оперштаба и отправиться гулять дальше?
Отвечаем на самые популярные вопросы, поступившие в редакцию НГС за последние дни.
Сейчас есть несколько тест-систем: одна из них — на COVID-19 (это название заболевания, которое дала ВОЗ коронавирусной инфекции) — выявляет наличие SARS-CoV-2 (вирус, являющийся возбудителем COVID-19) в биологическом материале человека в инкубационном периоде и активной фазе заболевания. Вторая ищет антитела к коронавирусу и тем самым позволяет выявить людей, которые переболели в лёгкой и бессимптомной форме.
По данным на 20 апреля, в Новосибирской области проведено 12 882 лабораторных исследования на COVID-2019.
То есть в этой статистике учтены только бесплатные тесты, которые эти лаборатории делают для госучреждений. Но сейчас появились и лаборатории в частных клиниках, которые делают тесты платно всем желающим.
В Роспотребнадзоре утверждают, что пациенты не смогут скрыть диагноз, и ссылаются на постановление главного санитарного врача от 30 марта 2020 года.
Некоторые новосибирцы, сдавшие анализ на коронавирус, уверяют, что их предупреждали — есть и пить перед тестированием нельзя. Другие говорят, что сдали тест без всякой подготовки — им ничего не говорили, никаких рекомендаций не давали. Как правильно — объяснили в Роспотребнадзоре:
— Ограничения, в том числе по режиму питания, для лиц, у которых отбирается материал для исследований на COVID-19, не предусмотрены.
Иными словами, неважно — поели вы перед сдачей анализа или нет. Так говорят в Роспотребнадзоре, однако некоторые частные клиники, принимающие анализы платно, предупреждают о том, что для прохождения процедуры у них всё же нужно не есть и не пить за несколько часов и не чистить зубы.
В редакцию НГС поступают жалобы, что анализы делают очень долго. Например, Михаил прилетел в Новосибирск из Москвы ещё до того, как решили делать тесты на коронавирус всем прилетевшим из столицы и Санкт-Петербурга, — 31 марта. У него в тот же день была температура 37,5 и другие симптомы.
— Скорая, приехавшая в тот же день, тестами не располагала. Врач очень сокрушалась, что людей неправильно ориентируют на горячей линии, что якобы забор может взять скорая помощь, вот они и перенаправили меня в лечебное учреждение по месту жительства, — говорит он.
Михаил живёт на улице 1905 года и относится к поликлинике № 20. 1 апреля к нему пришла медсестра, взяла материалы для анализа на коронавирусную инфекцию, а результаты, по его словам, всё ещё не готовы (прошло почти три недели). Хотя изначально Михаила предупреждали, что результаты будут готовы в течение пяти дней.
И он не один с такой историей. Другой новосибирец рассказал, что 20 марта прилетел из Турции. 30 марта у него взяли анализ на коронавирус. Результата тоже нет. Он живёт в Первомайской районе, в частном секторе. При этом в гостях у него была сестра из другого города, ей сделали тест 29 марта, когда она вернулась. Её результат уже готов — отрицательный.
У новосибирца Николая (имя изменено по его просьбе) взяли тест 6 апреля и тоже сказали, что результаты готовятся в течение трёх дней, а звонят только при положительном. Для успокоения он звонил через неделю, но они так и не были готовы, потому что, как ответили в поликлинике, на тот момент выполнялись анализы за конец марта.
— Сроки проведения исследований на новую коронавирусную инфекцию COVID-19 лабораториями медицинских организаций, допущенных к проведению исследований, зависят от технологических особенностей проведения ПЦР-исследований, — кратко ответили на вопрос НГС в Управлении Роспотребнадзора по Новосибирской области.
В Минздраве Новосибирской области также не смогли дать ответ, в течение скольки дней готовятся результаты анализов и почему могут происходить задержки.
Журналист НГС сдала тест, как только появилась возможность делать это платно всем желающим. Рассказываем, как это было. Только, не поверите, результаты её анализов также до сих пор не готовы.
Найдена информация об 1 подходящем медицинском центре. Какие анализы сдают на проверку коронавируса у человека? Как делают тест и как долго ждать результатов? Виды сдачи анализа. Цена анализа на коронавирус в клиниках города.





Лабораторная диагностика коронавируса
Коронавирусная инфекция — острое заболевание дыхательных путей, вызванное новым штаммом коронавируса COVID-2019 или SARS-CoV-2. Болезнь передается от больного человека здоровому через воздух и загрязненные предметы. У 15% возникает лихорадка, боль в горле, затрудненное дыхание, у 5% развивается тяжелая пневмония. В 80% случаев болезнь протекает бессимптомно либо в легкой форме, как обычная простуда.
С момента заражения до появления первых симптомов проходит около 14 дней. В этот период человек заразен для окружающих, а тест — единственный способ вовремя выявить заболевших и инфицированных без признаков заболевания. При положительном результате их изолируют на 2 недели.
На сайте Med-Firmika читайте, как и где берут анализ на коронавирус, сколько ждать результатов и в каких клиниках проводят исследование.

По каким показаниям делают тест на коронавирус
Тестирование на коронавирус проводят, если после обследования врач выявляет условия для заражения. Анализ необходим:
- Больным с признаками ОРВИ, бронхита или пневмонии, если они прибыли из страны, где зафиксирована эпидемия, а с момента приезда не прошло двух недель.
- Пожилым людям старше 60 лет, если у них есть признаки заражения;
- Лицам с хроническими заболеваниями при повышении температуры, кашле и одышке;
- Всем пациентам с симптомами пневмонии;
- Людям, которые в последние 14 дней общались с инфицированным;
- Лицам, ухаживающим за больными или людьми, помещенными на карантин.
Где сдать анализ на коронавирус?
Чтобы пройти тест на коронавирусную инфекцию, следует обратиться к врачу за направлением. Анализ берут в обычных поликлиниках, но делают только в лабораториях Роспотребнадзора.
Основной материал для исследования — мазок, взятый из носоглотки или зева. Мазки берут двумя разными тампонами: первым собирают материал из полости носа, а вторым — из ротоглотки. Чтобы повысить чувствительность исследования, взятые образцы собирают в одну пробирку. Реже используют цельную кровь или мокроту, которая выделилась при естественном отхаркивании.

Чтобы обнаружить коронавирус, используют два вида тестов:
- Полимеразную цепную реакцию или ПЦР мазка. Это основной метод диагностики COVID-2019, который проводят только в лабораторных условиях. ПЦР — молекулярно-генетическое исследование, с помощью которого можно обнаружить генетический материал вируса, даже если есть всего одна молекула возбудителя.
- Серологический экспресс-анализ крови. Его проводят с помощью тест-кассеты. Из пальца пациента берут кровь, затем через пипетку закапывают в специальную зону на кассете. Туда же добавляют 1-2 капли буферного раствора, который нужен, чтобы поддержать нужную среду на полоске теста, пока происходит реакции.
Если при заборе мазка допущена техническая ошибка или в крови еще нет антител к вирусу, исследования дают ложноотрицательные результаты. Людей с высоким риском инфицирования тестируют дважды с интервалом в несколько дней. А если у пациента есть признаки ОРВИ, исследование повторяют три раза.
При высокой температуре и других симптомах коронавирусной инфекции врач осматривает заболевшего на дому. В домашних условиях тестирование не проводят, но если есть риск, что болезнь вызвана коронавирусом, пациента госпитализируют в инфекционную больницу, независимо от тяжести состояния. Здесь у него берут мазок из зева и отправляют в лабораторию Роспотребнадзора либо делают экспресс-тест.
Как узнать результаты анализа на коронавирус
Результаты экспресс-теста можно получить в течение 10-15 минут. Если человек заражен, в длинном окошке кассеты появятся одна или две полоски:
ПЦР-тест — более точная диагностика в сравнении с экспресс исследованием. Однако вирус-специфические антитела можно обнаружить в крови и спустя месяцы после удаления вируса из организма, поэтому серологические исследования не заменяют ПЦР-диагностику, а дополняют ее.

Сколько стоит анализ на коронавирус в Новосибирске?
Тест на коронавирусную инфекцию можно пройти бесплатно в клиниках Роспотребнадзора, но только, если выявлены показания. Некоторые российские частные клиники предлагают платный анализ на коронавирус с помощью экспресс-тестов. ПЦР-тест проводят только в специализированной лаборатории, поскольку при исследовании есть риск распространения вируса.
Тестирование крови экспресс методом и ПЦР-диагностика мазка будут доступны только людям, без симптомов, желающим пройти обследование. Стоимость анализа составляет от 1 900 ₽ до 10 000₽. Результаты рапид-теста можно получить сразу, а анализ ПЦР займет от 2, но результаты могут прийти в течение 5 дней, поскольку нужно время на транспортировку биоматериала.
Список источников для статьи:
Шесть ветеринарных лабораторий Новосибирской области, имеющих допуск к работе с микроорганизмами второй группы патогенности, возможно, будут помогать врачам-инфекционистам — выполнять анализы на коронавирус. Вторая группа патогенности — это довольно опасные вирусы. Наряду с коронавирусом в этой группе ВИЧ, гепатит. Опаснее только первая группа, к которой отнесена лихорадка Эбола. Лабораторий и специалистов, имеющих допуск к работе с микроорганизмами второй группы патогенности, не так много.

Тем временем работники ветеринарной службы участвуют в дезинфекции предприятий, улиц и помещений. Например, в Усть-Тарке сотрудники местной госветслужбы дезинфицируют жилые дома, школы и находящийся в районе дом престарелых.
Однако главной задачей ветеринарных специалистов остается обеспечение населения качественной продукцией животного происхождения и защита населения от эпизоотий, то есть болезней, передающихся от животных к человеку.
Возвращаясь к теме коронавируса, Владимир Гоппе сообщил, что бушующая сегодня в мире инфекция не переходит от животных к человеку и наоборот. Информация о заражениях кошек и тигров, как заявил специалист, неофициальная.
— Ни одного официально подтвержденного факта заражения животных коронавирусом человека на сегодняшний день в мире нет, — подчеркнул он.

Также практически исключена возможность передачи коронавируса через продукты питания.
— На всех сельхозпредприятиях и предприятиях переработки Новосибирской области приняты беспрецедентные меры безопасности, учреждения работают в закрытом режиме. Чтобы зайти на птицефабрику, свиноферму или мясокомбинат, работники принимают душ, переодеваются в стерильную одежду. Автомобили, въезжающие на территорию этих предприятий и выезжающие с нее, проходят дезинфекцию. Сотрудники с признаками недомогания не допускаются к работе, — рассказал руководитель пресс-службы Управления ветеринарии Новосибирской области Юрий Шмидт. — Перед убоем каждое животное осматривает ветеринар, и, если есть какие-то признаки нездоровья, животное отстраняется от убоя. Таким образом, контоминация, то есть попадание патогенных микроорганизмов на продукты питания, практически исключена.
Иное дело, если вы покупаете мясо или молоко с рук. С мясом не так опасно, если только не есть его сырым.
Лучший друг вирусов — низкая температура. При воздействии высоких температур и ультрафиолета вирусы, которые могли попасть на мясо, например, от продавца, погибают, — объяснил Владимир Гоппе.
Молоко в этом смысле более опасный продукт. Многие употребляют его без термической обработки, считая, что парное молоко, которое, например, продают дачникам деревенские бабушки, очень полезно. На самом деле мир сегодня настолько инфицирован различными микроорганизмами, что покупать молоко у бабушек или мясо у дедушек просто опасно. И не потому, что там может оказаться коронавирус, а из-за множества других биологических опасностей, которые таят в себе такие продукты.
Эти биологические опасности могут в полной мере проявить себя с 19 апреля, когда в Новосибирской области закроют продуктовые рынки. Производители сельскохозяйственной продукции будут искать альтернативные пути сбыта, и количество сельчан, продающих мясо и молоко у дороги, увеличится. В этой связи специалисты еще раз призвали жителей не покупать продукты на автотрассах или в частных подворьях.
К другим биологическим опасностям относится, например, птичий грипп, от пандемии которого мир вздрогнул в 2003 году. Тогда умерли больше 900 человек. Сегодня против этой инфекции создана вакцина. Ее применяют на птицефабриках и в крестьянско-фермерских хозяйствах, занимающихся разведением кур, уток, гусей, индюков.

Однако дикие птицы, прилетающие в Новосибирскую область, могут оказаться разносчиками заразы. И в случае контакта с домашней птицей последствия могут быть самыми плачевными. Чтобы не допустить такого сценария, местные власти приняли решение запретить весеннюю охоту.
— В обычных условиях перелетные птицы селятся компактно. Мы знаем места их гнездования и раскладываем там приманки с вакциной — по аналогии с вакциной от бешенства. Но когда охотники начинают стрелять, они разгоняют птиц по всей территории области, — объяснил Юрий Шмидт.
Другая опасность весенней охоты — в людях. Специалисты убеждают: не нужно сейчас выезжать из города в районы области, перемещаться между районами, потому что человек со скрытой формой болезни может стать ее разносчиком.
Кроме птичьего гриппа, дикие животные на территории Новосибирской области могут быть источниками бешенства, сибирской язвы, трихинеллеза и еще целого ряда смертельно опасных заболеваний.
С начала 2020 года в регионе зафиксировано уже восемь случаев бешенства. В 2019-м за этот же период вспышек бешенства было 13.
Эпизоотий других опасных инфекций, к счастью, в этом году еще не было. Тем не менее специалисты ветеринарной службы предостерегают от охоты на медведя: каждый третий косолапый хищник в Новосибирской области заражен трихинеллезом. Это паразитарное заболевание, в большинстве случаев заканчивающееся летальным исходом. Источниками трихинеллеза могут быть также дикие кабаны и барсуки.
— Для обеспечения безопасности продукции АПК, которая поступает на стол жителей области, все партии продовольственного сырья и пищевых продуктов подвергаются ветеринарно-санитарной экспертизе. В течение суток специалисты госветслужбы области выдают более 300 тысяч электронных ветеринарных сертификатов, подтверждающих безопасность пищевых продуктов. Речь идет о мясе и мясопродуктах, молоке и молочных продуктах, рыбе и другом.
Пандемия COVID-19 не сдает своих позиций, ежедневно меняя статистику Всемирной организации здравоохранения малоутешительными цифрами. Проблема усугубляется тем, что отличить китайский вирус от обычного ОРВИ или гриппа без соответствующих лабораторных анализов невозможно. Человек в течение всего инкубационного периода болезни, который длится до двух недель, может не подозревать, что инфицирован, одновременно с этим представляя собой реальную угрозу для окружающих. Назревает главный вопрос – где сдать анализ на коронавирус в Новосибирске?
На вопрос отвечают врачи
Прежде, чем разъяснить, где сдать тест на коронавирус в Новосибирске, медики разъясняют несколько вопросов.
Всех жителей делят на четыре категории. В первую входят те, кому экспресс-тест необходим в обязательном порядке. Остальных проверяют по решению лечащего врача.

Распределение по категориям выглядит следующим образом:
Людям, прибывшим из стран, считающихся неблагополучными по количеству инфицированных жителей и проявляющим симптоматику ОРВИ, можно сдать анализ бесплатно.
Как проверяют на коронавирус? Биологический материал для исследования берется в виде мазков из ротовой полости и носа. На проверку могут направить людей, контактировавших с заболевшими коронавирусом.
Если возникает подозрение, что человек инфицирован китайским вирусом, его изолируют в инфекционный бокс вне зависимости от степени состояния пациента, и забор биоматериала для исследования выполняется в условиях стационара.
Обращаем внимание, что жителям, не выезжавшим за границу и не имевшим контактов с инфицированными, сдать анализ на наличие коронавируса самостоятельно не получится.
В аптечной сети тест-системы не реализуются, обычные отделения поликлиник соответствующего оснащения не имеют.

Тест-системы поставляются только в лаборатории Новосибирска, где можно пройти тест на коронавирус, частные клиники ими не обеспечиваются.
Схожесть симптоматики коронавируса с простудными заболеваниями, отсутствие возможности пройти диагностику всем желающим, продолжительность инкубационного периода вируса только увеличивают панические настроения. Желающим протестироваться самостоятельно в скором времени будет предложено несколько способов. Один из них – лаборатории Инвитро, руководство которых выразило желание запустить программу добровольной проверки на инфекцию.
Как только будут оформлены соответствующие разрешения, сотрудники лабораторий начнут принимать первых посетителей, изъявивших желание пройти тест платно. До того момента, пока оформляется лицензия, идет закупка тест-систем, готовится материально-техническая база лабораторных и офисных помещений.
В странах СНГ функционирует более 1 400 офисов и восемь лабораторий, пять из которых размещены в Москве, Новосибирске, Самаре, Челябинске, Санкт-Петербурге. Перечень офисов, где будут проводить забор биоматериалов и направлять их в одну из лабораторий для проверки, находится в стадии формирования и будет опубликован на официальном сайте на момент запуска проекта. Там же планируется размещение информации о том, какие анализы сдавать, и через сколько дней будет известен результат проверки.
Окончательная стоимость услуги не определена. Предполагается, что цена тестирования сформируется с учетом понесенных затрат на приобретение тестов и всего, что необходимо для исследований. Отметим лишь, что в приоритете стоит вопрос о минимизировании оплаты для посетителей, потому что проект в первую очередь преследует не коммерческие интересы, а носит скорее социальный характер. С его помощью планируется устранить панические настроения, вызванные неизвестностью, поддержать российскую здравоохранительную систему.
Тестирование проводится на основе метода ПЦР, который в лабораторных условиях выдает результаты в течение четырех часов. Но, принимая во внимание вопросы логистики и потенциальной загруженности, предполагается, что расчетные сроки подготовки результатов проверки не превысят двух рабочих дней.
В работе планируется пользоваться технологией ПРЦ, определяющей РНК вируса в соскобах. Именно этот способ сегодня используют в немногочисленных лабораторных пунктах Роспотребнадзора. Биологический материал будет отбираться из носа и полости рта, предварительная подготовка посетителя для этого не потребуется.
Главная особенность в том, что планируется круглосуточный забор биоматериалов, что позволит сдавать анализы в любое удобное время.
Обращаем внимание, что специфичность коронавируса достигает 98 %. Даже в инкубационный период он способен не выдавать своего присутствия характерными симптомами. Важно понимать, что на начальной стадии развития болезни показания тестов могут оказаться отрицательно ложными. В таких случаях рекомендуется отслеживать свое самочувствие, наблюдать динамику и через несколько дней сдать анализ повторно.
Заключение
График зараженных коронавирусом в Новосибирске
На сегодняшний день в Новосибирске 168 заболевших, всего в России заболело 72488, а в мире 2680514.
Статистика заражения коронавирусом в Роcсии
| Регион | Зара зивши еся | Умер шие | Выз доро вев шие | Леталь ность |
|---|---|---|---|---|
| Москва | 33940 + 1959 +5.7% | 288 | 2448 | 0.8% |
| Объединённые Арабские Эмираты | 8756 + 518 +5.9% | 56 | 1637 | 0.6% |
| Московская область | 7278 + 688 +9.4% | 56 | 186 | 0.7% |
| Санкт-Петербург | 2458 + 191 +7.7% | 17 | 368 | 0.6% |
| Нижегородская область | 1002 + 73 +7.2% | 7 | 60 | 0.6% |
| Кот-д’Ивуар | 952 | 14 | 310 | 1.4% |
| Мурманская область | 603 + 97 +16% | 3 | 61 | 0.4% |
| Ленинградская область | 576 + 39 +6.7% | 0 | 36 | 0% |
| Республика Коми | 542 + 15 +2.7% | 4 | 23 | 0.7% |
| Краснодарский край | 539 + 58 +10.7% | 14 | 88 | 2.5% |
| Ростовская область | 469 + 71 +15.1% | 0 | 18 | 0% |
| Тульская область | 461 + 25 +5.4% | 3 | 53 | 0.6% |
| Брянская область | 459 + 60 +13% | 2 | 68 | 0.4% |
| Республика Дагестан | 454 + 37 +8.1% | 11 | 43 | 2.4% |
| Республика Ингушетия | 436 + 39 +8.9% | 13 | 50 | 2.9% |
| Рязанская область | 429 + 37 +8.6% | 0 | 32 | 0% |
| Красноярский край | 427 + 35 +8.1% | 5 | 48 | 1.1% |
| Республика Башкортостан | 422 + 26 +6.1% | 14 | 38 | 3.3% |
| Республика Татарстан | 412 + 57 +13.8% | 0 | 33 | 0% |
| Республика Мордовия | 385 + 28 +7.2% | 1 | 13 | 0.2% |
| Калужская область | 383 + 53 +13.8% | 8 | 14 | 2% |
| Тверская область | 383 + 27 +7% | 0 | 15 | 0% |
| Республика Марий Эл | 348 + 15 +4.3% | 1 | 46 | 0.2% |
| Чеченская Республика | 347 + 24 +6.9% | 6 | 19 | 1.7% |
| Тюменская область | 341 + 22 +6.4% | 2 | 34 | 0.5% |
| Владимирская область | 339 + 46 +13.5% | 5 | 11 | 1.4% |
| Ставропольский край | 332 + 55 +16.5% | 5 | 38 | 1.5% |
| Хабаровский край | 310 + 38 +12.2% | 5 | 19 | 1.6% |
| Курская область | 308 + 32 +10.3% | 3 | 27 | 0.9% |
| Республика Чувашия | 305 + 43 +14% | 5 | 14 | 1.6% |
| Пермский край | 287 + 21 +7.3% | 4 | 43 | 1.3% |
| Оренбургская область | 277 + 23 +8.3% | 2 | 32 | 0.7% |
| Свердловская область | 271 + 28 +10.3% | 1 | 65 | 0.3% |
| Ярославская область | 263 + 65 +24.7% | 1 | 18 | 0.3% |
| Тамбовская область | 263 + 23 +8.7% | 0 | 25 | 0% |
| Воронежская область | 261 + 25 +9.5% | 7 | 30 | 2.6% |
| Смоленская область | 251 + 7 +2.7% | 2 | 4 | 0.7% |
| Орловская область | 249 + 11 +4.4% | 2 | 10 | 0.8% |
| Ямало-Ненецкий автономный округ | 243 + 94 +38.6% | 1 | 22 | 0.4% |
| Республика Северная Осетия — Алания | 242 + 31 +12.8% | 2 | 18 | 0.8% |
| Кировская область | 240 + 24 +10% | 3 | 20 | 1.2% |
| Ивановская область | 239 + 14 +5.8% | 2 | 12 | 0.8% |
| Липецкая область | 238 + 25 +10.5% | 2 | 62 | 0.8% |
| Саратовская область | 229 + 39 +17% | 0 | 19 | 0% |
| Ульяновская область | 228 + 32 +14% | 2 | 5 | 0.8% |
| Кабардино-Балкарская Республика | 218 + 25 +11.4% | 1 | 15 | 0.4% |
| Ханты-Мансийский АО | 215 + 12 +5.5% | 1 | 36 | 0.4% |
| Пензенская область | 211 + 15 +7.1% | 5 | 6 | 2.3% |
| Приморский край | 185 + 19 +10.2% | 2 | 13 | 1% |
| Белгородская область | 176 + 32 +18.1% | 2 | 13 | 1.1% |
| Калининградская область | 171 + 8 +4.6% | 1 | 45 | 0.5% |
| Карачаево-Черкесская Республика | 169 + 24 +14.2% | 0 | 1 | 0% |
| Новосибирская область | 168 + 17 +10.1% | 4 | 23 | 2.3% |
| Волгоградская область | 165 + 20 +12.1% | 2 | 31 | 1.2% |
| Астраханская область | 165 + 17 +10.3% | 3 | 25 | 1.8% |
| Республика Бурятия | 163 + 10 +6.1% | 2 | 55 | 1.2% |
| Удмуртская Республика | 161 + 9 +5.5% | 3 | 18 | 1.8% |
| Новгородская область | 157 + 17 +10.8% | 1 | 6 | 0.6% |
| Алтайский край | 144 + 8 +5.5% | 0 | 13 | 0% |
| Самарская область | 141 + 26 +18.4% | 0 | 15 | 0% |
| Республика Саха (Якутия) | 128 + 12 +9.3% | 0 | 17 | 0% |
| Архангельская область | 123 + 3 +2.4% | 1 | 18 | 0.8% |
| Вологодская область | 120 + 6 +5% | 0 | 23 | 0% |
| Республика Адыгея | 114 + 1 +0.8% | 3 | 32 | 2.6% |
| Челябинская область | 111 + 9 +8.1% | 0 | 38 | 0% |
| Костромская область | 104 + 16 +15.3% | 2 | 11 | 1.9% |
| Республика Хакасия | 99 + 12 +12.1% | 0 | 8 | 0% |
| Республика Калмыкия | 94 + 6 +6.3% | 3 | 14 | 3.1% |
| Камчатский край | 78 + 15 +19.2% | 0 | 5 | 0% |
| Магаданская область | 76 + 9 +11.8% | 0 | 2 | 0% |
| Иркутская область | 75 | 3 | 21 | 4% |
| Кемеровская область | 67 + 11 +16.4% | 1 | 11 | 1.4% |
| Псковская область | 66 + 4 +6% | 6 | 9 | 9% |
| Еврейская автономная область | 66 + 14 +21.2% | 0 | 6 | 0% |
| Забайкальский край | 64 + 3 +4.6% | 0 | 5 | 0% |
| Омская область | 53 + 8 +15% | 0 | 19 | 0% |
| Томская область | 52 + 9 +17.3% | 0 | 4 | 0% |
| Республика Крым | 51 + 5 +9.8% | 0 | 23 | 0% |
| Республика Карелия | 35 + 5 +14.2% | 0 | 1 | 0% |
| Амурская область | 25 + 2 +8% | 0 | 5 | 0% |
| Севастополь | 25 + 6 +24% | 0 | 5 | 0% |
| Курганская область | 20 + 5 +25% | 0 | 3 | 0% |
| Сахалинская область | 19 | 0 | 8 | 0% |
| Республика Тыва | 14 + 1 +7.1% | 0 | 0 | 0% |
| Республика Алтай | 9 + 1 +11.1% | 0 | 0 | 0% |
| Сахарская Арабская Демократическая Республика | 6 | 0 | 5 | 0% |
| Чукотский автономный округ | 6 | 0 | 0 | 0% |
| Ненецкий автономный округ | 1 | 0 | 0 | 0% |
| Йемен | 1 | 0 | 0 | 0% |
Жители Новосибирска и люди, приехавшие сюда по личным или служебным делам, хотят знать, как в городе обстоят дела с выявлением и распространением COVID-19.
Коронавирус в Новосибирске: сколько заболевших, закрыт ли на карантин
В инфекционной больнице №1 сейчас проходят лечение 50 человек, имеющих симптомы ОРВИ. Все они вернулись в РФ из-за рубежа. Тесты, сданные на COVID-19, у 30 пациентов оказались отрицательными, а у 15 человека еще обрабатываются.
На днях в детскую больницу №3 был доставлен ребенок, у которого выявлены легкие признаки ОРВИ. Он находился на одном борту самолета с инфицированным гражданином. Пока в этом медучреждении пребывают 7 детей, сдавших анализы на выявление коронавируса.
По всей области на домашнем карантине находятся 3817 граждан. Это здоровые люди, недавно вернувшиеся на родину либо контактировавшие с зараженными.
Как и по всей стране, ситуация с коронавирусом в Новосибирске взята под особый контроль. Нерабочая неделя продлится вплоть до 5 апреля. Местные власти объявили о том, что метро и наземный транспорт будут доступны горожанам, но для них подготовят специальный график. Школы переведены на дистанционное обучение.
Заразившийся спортсмен и застрявшие туристы
Сибирякам, находящимся за границей в столь сложный для всего мира период, точно не повезло. За билет обратно домой им приходится платить в 3-5 раз больше, чем стоила путевка в другую страну.
Заболевший кот обрел дом
Новосибирский котик рыжего окраска, у которого выявили коронавирус, теперь больше не бездомный. У представителей семейства Кошачьих данное заболевание довольно распространено. И никакой опасности для людей не представляет.

Рыжий кот по кличке Тольятти обрел семью в лице молодой супружеской четы. Они связались с волонтерами, узнали о привычках животного и решили забрать его себе. Коту понравились новые хозяева.
Читайте также:
- Сколько человек в новом уренгое болеют коронавирусом
- Коронавирус как политический инструмент
- Китай коронавирус задержание
- Найдена сыворотка от коронавируса
- Ростуризм коронавирус япония


